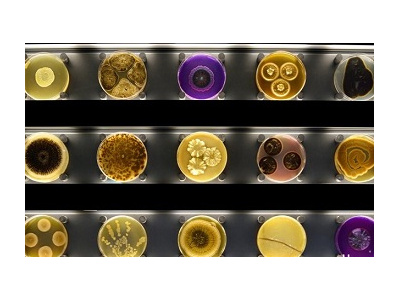
بانک ژن گیاهی و میکروارگانیسم ها

بهینه سازی و فرآوری گیاهان دارویی
محصول کاربردها و مصارف:تولید مواد اولیه صنعت داروهای گیاهی کشور نام واحد:یاسوج پژوهشکده گیاهان دارویی نحوه تماس و ثبت سفارش: معاونت پژوهشی یاسوج پژوهشکده گیاهان دارویی مصرف کنندگان:صنعت دارو کشور...
اهلی سازی گیاهان دارویی
خدمت کاربردها و مصارف: توسعه کشت گیاهان دارویی نام واحد: ایلام لرستان نحوه تماس و ثبت سفارش:ایلام لرستان مصرف کنندگان: بخش خصوصی ستاد توسعه گیاهان دارویی کارفرما:ستاد توسعه گیاهان دارویی گروه ها...
فرآوري مواد غذايي
محصول کاربردها و مصارف: تولید مواد غذایی با هدف بهبود سلامت نام واحد: مشهد نحوه تماس و ثبت سفارش: مشهد مصرف کنندگان:مشهد کارفرما:مشهد گروه های استفاده کنندگان(گیرندگان خدمات):مشهد اطلاعات هماهن...
کيفيت و ايمني مواد غذايي
خدمت کاربردها و مصارف: افزایش کیفیت نام واحد:مشهد نحوه تماس و ثبت سفارش: مشهد مصرف کنندگان: بخش خصوصی صنایع غذایی کارفرما:بخش خصوصی صنایع غذایی گروه های استفاده کنندگان(گیرندگان خدمات):بخش خصوصی...
افزودنيهاي غذايي
تولید رنگهای خوراکی با منشاء طبیعی فرمولاسیون روغن سرخکردنی با ویژگیهای پایداری بالا برای یکی از واحدهای تولیدی تولید همبرگر رژیمی کمچرب به سفارش یک واحد تولیدی بهینهسازی سوسیس رژیمی بهبود...
بانک ژن گیاهی و میکروارگانیسم ها
خدمت کاربردها و مصارف: تولید نمونه گیاهی و میکرو ارگانیسم ها نام واحد: مرکز ملی ذخائر نحوه تماس و ثبت سفارش: مرکز ملی ذخائر مصرف کنندگان: دانشگاه ها و مرا کز پژ<هشی کارفرما:دانشگاه و مرا کز پژ...
بذرهای هیبریدی
محصول کاربردها و مصارف:تولید سبزی و صیفی نام واحد: مرکز ملی ذخائر جهاد دانشگاهی نحوه تماس و ثبت سفارش:مرکز ملی ذخائر جهاد دانشگاهی مصرف کنندگان: تولید کنندگان سبزی و صیفی کارفرما: بخش خصوصی جهاد...
مهندسی ژنتیک گیاهی و جانوری
تولید فرآوردههای صنعتی در حوزههای غذایی، کشاورزی، پزشکی و محیط زیست مبتنی بر بیوتکنولوژی تولید ارقام و لاین های برتر گیاهان دارویی از طریق روشهای کلاسیک و نوین ارتقاء توان ژنتیکی گیاهان دارویی...
تکثیر گیاهان با روش کشت بافت
محصول کاربردها و مصارف:گیاهان دارویی نام واحد: پژوهشکده گیاهان دارویی جهاد دانشگاهی مصرف کنندگان: بخش خصوصی- وزارت جهاد کشاورزی - غذا و دارو کارفرما:بخش خصوصی- وزارت جهاد کشاورزی - غذا و دارو گرو...
تولید قارچهای خوراکی و دارویی
محصول کاربردها و مصارف: صنعت غذا و دارو نام واحد:جهاد دانشگاهی واحد مشهد نحوه تماس و ثبت سفارش: جهاددانشگاهی واحد مشهد مصرف کنندگان:غذاو دارو کارفرما:بخش خصوصی غذا و دارو گروه های استفاده کنندگا...
پرورش و تولید نیمه صنعتی جلبک اسپیرولینا
مکمل غذایی طیور و آبزیان افزایش رشد کاهش ضریب تبدیل غذایی (کلسترول و تریگلیسرید) افزایش سیستم ایمنی کاهش تلفات در مزارع تولید محصول کاربردها و مصارف: صنعت آبزی پروری و دام پروری نام واحد...
تولید متابولیتهای ثانویه در محیط بیورآکتور
محصول کاربردها و مصارف: تولید دارو نام واحد:ارومیه نحوه تماس و ثبت سفارش: ارومیه مصرف کنندگان: سازمان غذا و دارو کارفرما: بخش خصوصی غذا و دارو گروه های استفاده کنندگان(گیرندگان خدمات):بخش خصوصی...